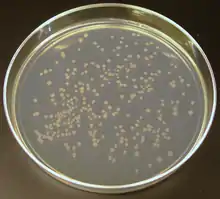

Gélose nutritive
En biologie, la gélose nutritive ou gélose nutritive ordinaire (GNO) ou encore gélose ordinaire est un milieu d'isolement non sélectif.
L'isolement est réalisé dans le but de contrôler la pureté d'une souche bactérienne (pur s'il y a un type de colonie sur la gélose) ou de purifier la souche bactérienne si elle est contaminée.
L'isolement permet de séparer des microorganismes différents dans un mélange qui pourront être ainsi étudiés individuellement.
Sur cette gélose nutritive, on observe le nombre de colonies différentes (nombre de type de colonies) et on fait une description des colonies isolées.
Ensemencement
    
Pour ensemencer, il s'agit de faire un dégradé sur toute la gélose afin d'isoler plusieurs colonies. Pour cela, avec une anse de platine, prélever une petite goutte de suspension bactérienne puis faire des stries serrées sur la moitié de la boîte de Petri. Ensuite tourner d'un quart de tour la boite, recommencer les stries. Ensuite tourner encore la boite d'un quart de tour et refaire encore les stries. De cette manière, toute la boite doit avoir été ensemencée ; attention à ne pas brûler la gélose lorsque l'anse est encore très chaude.
Examen macroscopique
    
- Taille des colonies
 - Contour
 - Relief
 - Surface
 - Consistance
 - Transparence
 - Pigmentation
 - Type des colonies
 - Exigence
 
Incubation 24/48 heures à 37 °C.
Usage
    
Milieu d'isolement courant surtout utilisé pour la recherche de flore mésophile aérobie revivifiable (FMAR).
Composition
    
- Extrait de viande : 1,0 g/L
 - Extrait de levure : 2,5 g/L
 - Peptone : 5,0 g/L
 - Chlorure de sodium : 5,0 g/L
 - Agar-agar : 15,0 g/L
 
- pH = 7,0
 
Préparation
    
28 g/L (stérilisation à l'autoclave).
Liens externes
    
- « Gélose nutritive après incubation »(Archive.org • Wikiwix • Archive.is • Google • Que faire ?)
 
- Portail de la microbiologie